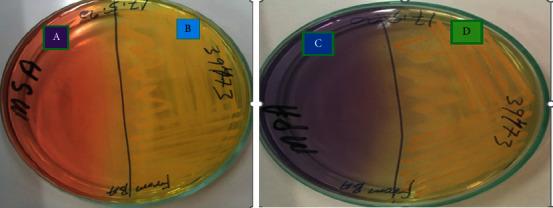
https://cdn.ncbi.nlm.nih.gov/pmc/blobs/0d20/8494582/2cf16aa2419a/VMI2021-1772658.002.jpg

塞贝塔镇奶牛场临床乳腺炎病原菌的分离、鉴定及药敏谱分析
Isolation, Identification, and Antimicrobial Susceptibility Profiles of from Clinical Mastitis in Sebeta Town Dairy Farms.
作者信息
Grima Letebrhan Yimesgen W, Leliso Shubisa Abera, Bulto Abebe Olani, Ashenafi Debebe
机构信息
National Animal Health Diagnostic and Investigation Center (NAHDIC), Sebeta, Ethiopia.
Addis Ababa University, College of Veterinary Medicine and Agriculture Debebe Ashenafi, Addis Ababa, Ethiopia.
出版信息
Vet Med Int. 2021 Sep 29;2021:1772658. doi: 10.1155/2021/1772658. eCollection 2021.
A cross-sectional study was carried out in and around Sebeta town dairy farms, Finfinne special zone, Ethiopia, from December 2019 to May 2020 to isolate, identify, and test antimicrobial susceptibility profile of from clinical mastitis. A total of 116 milk samples were purposively collected from 57 lactating cows with clinical mastitis. Isolation and identification of were carried out by using primary and secondary biochemical tests. Besides, Biolog was used for microbial identification systems. To know if the isolates develop resistance to antibiotics, the antimicrobial susceptibility test (ATS) was performed on Mueller-Hinton agar by the disk diffusion method. From a total of 57 lactating cows and 116 teat quarters examined, 21.05% (12/57) and 15.52% (18/116) were positive for . from clinical mastitis, respectively. From a total of 116 milk samples collected, 15.52% (18/116) were isolated, and from 11 farms surveyed, about 72.72% (8/11) overall farm prevalence of clinical mastitis due to . was recorded. All the 18 isolates were found susceptible to sulphamethoxazole/trimethoprim, erythromycin, gentamicin, ciprofloxacin, and chloramphenicol. However, high level of resistance was observed to common drugs such as penicillin (88.89%, 16/18) and tetracycline (61.11%, 11/18). The observed high level of resistance to penicillin and tetracycline also indicates the need to visit our treatment guidelines for mastitis caused by . Therefore, improved management and early treatment of the cases with drug of choice after the antimicrobial susceptibility test for each specific case can reduce chance of further development of resistance and are imperative to tackle clinical mastitis occurring at Sebeta and other similar farms in Ethiopia.
2019年12月至2020年5月,在埃塞俄比亚芬芬内特区塞贝塔镇及其周边的奶牛场开展了一项横断面研究,以分离、鉴定临床乳腺炎的病原菌并检测其抗菌药物敏感性。从57头患有临床乳腺炎的泌乳奶牛中,有目的地采集了116份乳样。通过一级和二级生化试验进行病原菌的分离和鉴定。此外,使用Biolog微生物鉴定系统。为了解分离株是否对抗生素产生耐药性,采用纸片扩散法在穆勒-欣顿琼脂上进行抗菌药物敏感性试验(ATS)。在总共检查的57头泌乳奶牛和116个乳区中,临床乳腺炎的病原菌阳性率分别为21.05%(12/57)和15.52%(18/116)。在总共采集的116份乳样中,分离出15.52%(18/116)的病原菌,在所调查的11个农场中,因该病原菌导致的临床乳腺炎总体农场患病率约为72.72%(8/11)。发现所有18株分离株对磺胺甲恶唑/甲氧苄啶、红霉素、庆大霉素、环丙沙星和氯霉素敏感。然而,观察到对青霉素(88.89%,16/18)和四环素(61.11%,11/18)等常用药物有较高水平的耐药性。观察到的对青霉素和四环素的高耐药水平也表明需要审视我们针对该病原菌引起的乳腺炎的治疗指南。因此,在对每个具体病例进行抗菌药物敏感性试验后,采用首选药物进行改进管理和早期治疗,可以减少耐药性进一步发展的机会,对于应对埃塞俄比亚塞贝塔及其他类似农场发生的临床乳腺炎至关重要。